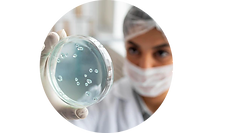
Ion--Gasometria.png

top of page

REAGENTES E INSUMOS
Suporte na implantação dos reagentes, zelo na logística e conservação dos mesmos fazem da CliniLab um fornecedor que atende as exigências e expectativas de mercado. Uma linha completa de reagentes e insumos selecionados, sempre com estoque presente para atender o seu laboratório. Reagentes para Bioquímica, Turbidimetria, Testes rápidos, Hematologia, Hemostasia, assim como insumos descartáveis para as fases pré-analítica e analítica do laboratório.
Veja relação dos insumos e reagentes disponíveis.:

bottom of page